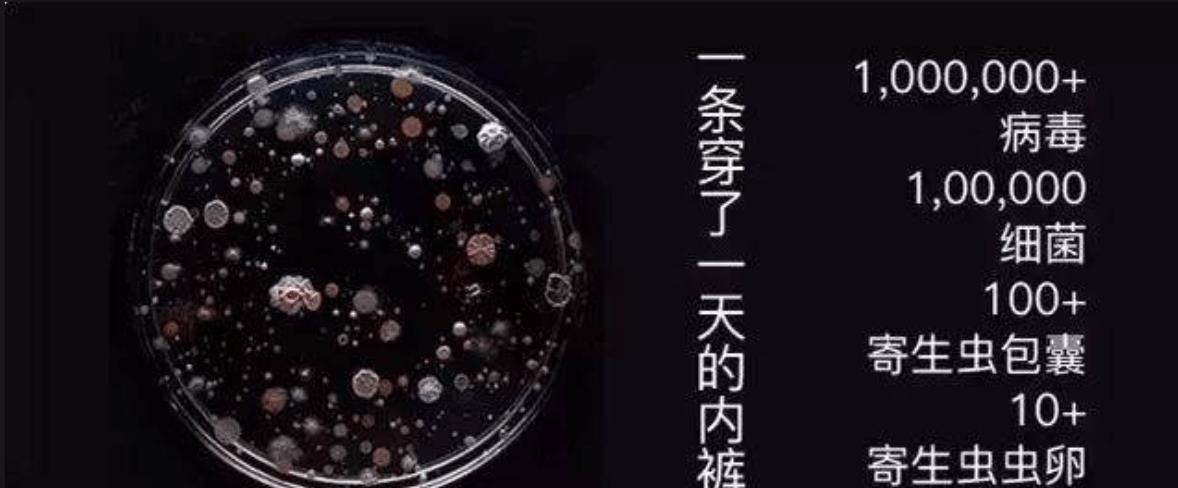
上热门迷你洗衣机,迷你洗衣机推荐性价比高小型

内衣洗衣机推荐:从选购角度出发,保障健康作为一种专门为内衣而设计的家电,内衣洗衣机的选择非常关键。在现有市场上,内衣洗衣机的种类繁多,功能也各不相同,让消费者十分困惑。因此,选购一款真正适合自己的内衣洗衣机变得尤为重要。本篇文章将为大家推荐一些测评使用体验较好的内衣洗衣机,并强调内衣清洗的重要性。内衣清洗的重要性内衣是我们日常生活中不可或缺的衣物之一,但我们可能经常忽略清洗它的重要性。手洗内衣裤五分钟,*裤内**上还残留着大约259菌落数,完全没有洗干净,而水泡就更加不可取了,会使菌落繁殖,泡水两小时菌落数大约在400左右。因此,内衣裤在清洗时需要特别注意清洁度。机洗内衣裤,菌落数大约在70左右,如果使用专业的内衣洗衣机除菌率可以在99%以上。内衣裤洗不干净对于我们的身体影响很大,即使一个人的免疫力相对较强,也难以完全抵御细菌的侵袭,这可能导致各种疾病的发生。
女性,如果*裤内**清洗不到位,可能会引发妇科疾病,例如尿路感染和阴道炎症等。而男性,可能会出现前列腺问题。因此,保持*裤内**清洁对于预防这些疾病至关重要。内衣洗衣机推荐1.希亦CEYEE-ACE内衣洗衣机在内衣洗衣机的选择上,最重要的是洗衣机的清洁除菌效果。希亦CEYEE-ACE内衣洗衣机是一款非常值得推荐的产品。它采用95℃高温煮洗,妇科细菌除菌率高达99.99%,是公认最“硬核”的洗护家电品牌。CEYEE希亦有着丰富的家电“洗护”设计及研发经验,希亦早年主要是给多家知名家电洗衣机、洗地机品牌提供专业清洁“洗护”方面技术解决方案。因此,CEYEE-ACE小型洗衣机具有很强劲的技术实力支撑。一些品牌只强调清洁能力,忽略了衣物的护理效果,而CEYEE-ACE小型洗衣机是真正做到了洗护一体,99.9%的高效除菌率,以及0.01%的低损衣率,做到高清洗低损耗的清洗效果。

对于注重生活品质和洗涤质量的用户,CEYEE-ACE内衣洗衣机是值得推荐的。2. Haier/海尔 C1内衣洗衣机海尔C1内衣洗衣机采用了智能洗涤系统,让用户可以根据洗涤需求自由选择洗衣模式。它还配备了除菌消毒系统,可以在洗涤过程中杀死细菌,保证洗衣的清洁度。海尔C1内衣洗衣机可以洗涤各种不同面料的衣物,包括羊毛、棉、麻、丝等材质的衣物。此外,它还具有超静音的特点,让用户在洗衣的同时不会受到噪音的干扰。3. LG/乐金 FH2G7QDY5内衣洗衣机LG FH2G7QDY5内衣洗衣机是一款高端产品,可以满足用户的各种洗涤需求。它采用蒸汽洗涤技术,可以在洗涤过程中杀死细菌,并能够使衣物更加柔软、舒适。此外,LG FH2G7QDY5内衣洗衣机还有除皱烘干功能,方便用户在短时间内完成洗涤、烘干、熨烫等一系列操作。它还配备了智能诊断系统,可以自动诊断故障,并提供解决方案。

总结内衣洗衣机的选择非常关键,它应该具备清洁除菌的效果。在选购时,需要根据自己的实际需求和预算进行选择。希亦CEYEE-ACE内衣洗衣机、海尔C1内衣洗衣机、LG FH2G7QDY5内衣洗衣机都是比较不错的选择,当然还有其他品牌的内衣洗衣机也值得关注。在日常使用时,需要注意内衣的清洁和保养,定期清洗内衣洗衣机,保证其正常运转,以便更好地为我们的生活服务。提醒:内衣清洗对于我们的身体很重要,但洗的过程也需要注意卫生,建议在洗涤时使用手套,避免直接接触内衣。内衣洗衣机市场的崛起和消费者的需求不断提升,给这个行业带来了新的机遇和挑战。然而,市面上的内衣洗衣机普遍存在清洁力欠佳的问题,这让人们开始寻找更加高效和可靠的解决方案。

希亦公司推出的CEYEE-ACE内衣洗衣机,采用了“军工级”的产品研发思维和多年的清洁技术经验,通过独特的WBS超能气泡清洗技术,彻底改变了传统的抛洗锤打洗涤方式,提供了更加强大的清洁能力。除了卓越的清洁能力,CEYEE-ACE内衣洗衣机在基础配置上也下了大功夫。它采用了顶尖的配置和四重减震技术,使得洗衣机更加可靠、平衡、低噪音。这不仅为用户提供了更好的使用体验,还延长了洗衣机的使用寿命。此外,CEYEE-ACE内衣洗衣机还具有多种杀菌模式,能够满足不同衣物的洗护需求。它的99.99%细菌去除率和100%的除螨率,为用户提供了更加健康和安全的洗涤保障。与此同时,RUUFFY小云舱内衣洗衣机也备受关注。它的外观设计独特,呈现出一种太空舱的感觉,不仅美观,还能够融入各种家居风格中,提升整体空间的时尚度。

在功能方面,RUUFFY小云舱内衣洗衣机拥有多种消毒杀菌模式,包括常见的高温煮洗、紫外线杀菌和纳米银离子杀菌。与其他内衣洗衣机相比,它还配置了独家的羟基冷水杀菌技术,使得即使在冷水条件下也能够有效杀灭微生物细菌。此外,RUUFFY小云舱内衣洗衣机还具备一键快洗功能,能够在短时间内完成清洗,方便快捷。总的来说,内衣洗衣机市场的需求不断增加,消费者对产品的质量和功能要求也越来越高。CEYEE-ACE内衣洗衣机和RUUFFY小云舱内衣洗衣机都是在不同方面具有优势和特色的产品,它们能够满足消费者在不同场合下的需求。然而,随着洗衣机市场的不断扩大,竞争也越来越激烈,产品的性能和功能也面临着不断提升的压力。未来的内衣洗衣机市场需要不断创新,提高产品的质量和性能,以满足消费者越来越高的需求。

除了更加强大的清洁能力和杀菌功能,内衣洗衣机还可以考虑加入更多智能化的功能,如智能控制、远程操作等,为用户带来更加便捷和舒适的使用体验。此外,厂商还应该加强售后服务,及时解决用户在使用过程中遇到的问题,提高用户的满意度和忠诚度。在不断追求产品性能和功能的同时,我们也要关注产品的环保性和可持续发展。内衣洗衣机可以加入节能模式和水资源管理系统,减少能源的消耗和水资源的浪费。此外,厂商还应该注重产品的生命周期管理,降低废弃物的产生,推动循环经济的发展。内衣洗衣机市场的发展离不开消费者的支持和反馈。作为消费者,我们对于内衣洗衣机有哪些期待和需求?你对于CEYEE-ACE内衣洗衣机和RUUFFY小云舱内衣洗衣机有何看法?你认为内衣洗衣机市场的未来会朝着怎样的方向发展?欢迎留言分享你的想法和看法。内衣洗衣机:选购攻略内衣作为女性最贴身的衣物之一,需要更加细致和专业的清洗方式。
因此,内衣洗衣机应运而生。在市场上,有多款不同品牌的内衣洗衣机,如何选购一款符合自己需求的内衣洗衣机呢?一、三大品牌内衣洗衣机测评在市场上,三大品牌内衣洗衣机拥有很高的关注度,分别是海尔、Panasonic和苏泊尔。这三大品牌的内衣洗衣机功能齐全,品质有保证,用户评价也较高。其中,海尔内衣洗衣机的洗涤效果较好,Panasonic内衣洗衣机则具有持久的耐用性,苏泊尔内衣洗衣机的设计比较人性化,但其价格相对较高。二、内衣洗衣机选购指南1. 容量大小:内衣洗衣机的容量以1-2kg为主,用户需要根据自己的需求选择不同的容量大小。一般而言,家庭中1-2人的内衣可以选择1kg容量的内衣洗衣机,家庭中3-4人的内衣可以选择2kg容量的内衣洗衣机。2. 清洗模式:内衣洗衣机的清洗模式需要根据自己的需求进行选择。
一些内衣洗衣机配备了多种清洗模式,如快速洗、煮洗、滚筒翻转洗等,用户可以根据自己的需求购买。3. 节能环保:内衣洗衣机的节能环保程度也是选购时需要考虑的重要因素。一些内衣洗衣机采用智能控制技术,可自动调节清洗水量和洗涤时间,达到节能环保的目的。4. 操作简便:内衣洗衣机的操作是否简便也是选购时需要考虑的因素之一。一些内衣洗衣机的操作界面设计简单,使用方便,用户可以轻松掌握。三、内衣洗衣机推荐1. 小狗内衣洗衣机小狗内衣洗衣机是一款小巧玲珑的内衣洗衣机,外观可爱,操作简便。其内置的洗衣桶采用了立体旋涡花纹设计,能够更好的去除内衣上的污渍。同时,小狗内衣洗衣机还配备了手机APP,用户可以通过连接APP解锁更多清洗模式,进行个性化设置,十分方便实用。2. 格兰仕内衣洗衣机格兰仕内衣洗衣机采用了革命性的“蒸汽洗涤”技术,比传统洗涤方式更加环保节能,而且洗涤效果更佳。
此外,格兰仕内衣洗衣机还配置了多种洗涤模式,如煮洗、洗涤、漂洗、脱水等,用户可以根据自己的需求进行选择。3. 荣事达内衣洗衣机荣事达内衣洗衣机采用PC+ABS材质外壳,耐用且外观圆润有光泽。其内置的洗衣桶底部采用了旋翼波轮设计,桶壁采用交错式花纹材质,耐磨且清洗更干净。荣事达内衣洗衣机的清洗水温有两档可选择,45度洗可去除灰尘污渍,80度洗可去除绝大部分细菌。除此之外,洗衣机还配置了紫外线杀菌功能,可处理发霉衣物,达到消杀作用。4. 美菱内衣洗衣机美菱内衣洗衣机外观颜值较高,具有灵敏的全息触控面屏,可一键唤醒。此外,美菱内衣洗衣机可加热到80-90度左右的高温,通过高温蒸汽雾化衣物达到有效剥离细菌,达到高温杀菌除螨的功效。美菱内衣洗衣机还具有洗衣桶自洁功能,可对桶内进行清洗,减少桶内残留细菌问题。另外,洗衣机还具有22分钟快速洗功能,省时高效。
5. 摩鱼内衣洗衣机摩鱼内衣洗衣机外观简约,具有95度高温煮洗功能,能有效清除衣物上的细菌,确保衣物的清洁和健康。此外,摩鱼内衣洗衣机还具有较好的脱水功能,是一款性价比较高的内衣洗衣机。总的来说,选购内衣洗衣机需要根据自己的需求进行选择。在品牌方面,海尔、Panasonic和苏泊尔是三大品牌,而在具体型号上,小狗、格兰仕、荣事达、美菱和摩鱼都是不错的选择。无论选择哪一款内衣洗衣机,都需要注意其容量大小、清洗模式、节能环保和操作简便等因素。内衣洗衣机:为你的内衣保驾护航摩鱼内衣洗衣机的上市,为内衣清洗领域注入了新的血液。相比传统洗衣机,内衣洗衣机不仅洗涤效果更佳,而且采用了更适合内衣清洗的设计。那么,摩鱼内衣洗衣机的优点究竟有哪些呢?内桶全不锈钢,保证干净整洁为了保证洗衣过程的顺利进行,摩鱼内衣洗衣机内桶采用了全不锈钢材质。
相比塑料或者其他金属材质,不锈钢具有低磨损、不勾丝、使用寿命长等优点。此外,不锈钢还能够保持桶内干净整洁,有效防止细菌滋生,让你的内衣更加健康。650转极速脱水,提升洗衣效率内衣洗衣机的洗涤程序更为精细,比如摩鱼内衣洗衣机的650转极速脱水功能。该功能能在短短的七分钟内甩干衣物,大大提高了洗衣效率。对于生活节奏比较快的人来说,这个功能无疑是非常实用的。三重防位移系统,保证洗衣机的稳定性然而,高速脱水时的晃动问题,一直是内衣洗衣机的一个难点。为了解决这个问题,摩鱼特别配置了三重防位移系统。这个系统由减震垫、反力支撑和高强度支架三部分组成,能够有效地稳定洗衣机,避免晃动,保护你的内衣。55分贝低噪音,只为更好的生活关于噪音问题,不少人都有所担忧。但是,摩鱼内衣洗衣机在运行过程中的噪音控制在55分贝左右,几乎不会对日常生活造成影响。
不再有嘈杂的声音,你可以在洗衣的同时,享受着更加安静的生活。结语内衣是我们生活中必不可少的一部分,保持内衣的清洁和卫生,对我们的健康至关重要。摩鱼内衣洗衣机的上市,让我们的内衣清洗不再是一个难题。从内桶全不锈钢,到650转极速脱水;从三重防位移系统,到55分贝低噪音,摩鱼内衣洗衣机的每一个细节,都为你的内衣保驾护航。你还在等什么?赶快拥有一台属于自己的内衣洗衣机吧!你对内衣洗衣机有什么看法?欢迎在评论区留言,与我们分享。